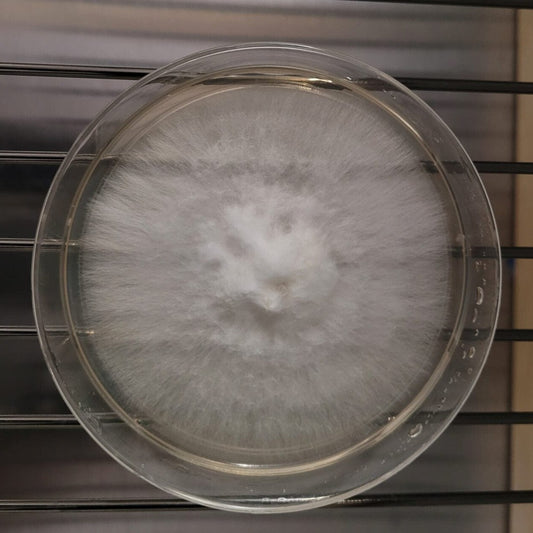
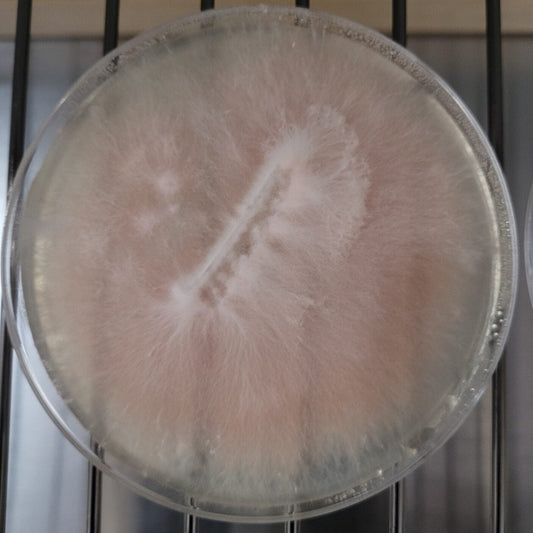

Collection: Agar Cultures
-
Lion's Mane (Hericium erinaceus) Agar Culture
Regular price $24.95 CADRegular priceUnit price / per -
Blue Oyster (Pleurotus ostreatus columinus) Agar Culture
Regular price $24.95 CADRegular priceUnit price / per -
Pink Oyster (Pleurotus djamor) Agar Culture
Regular price $24.95 CADRegular priceUnit price / per -
Chestnut (Pholiota Adiposa) Agar Culture
Regular price $24.95 CADRegular priceUnit price / per